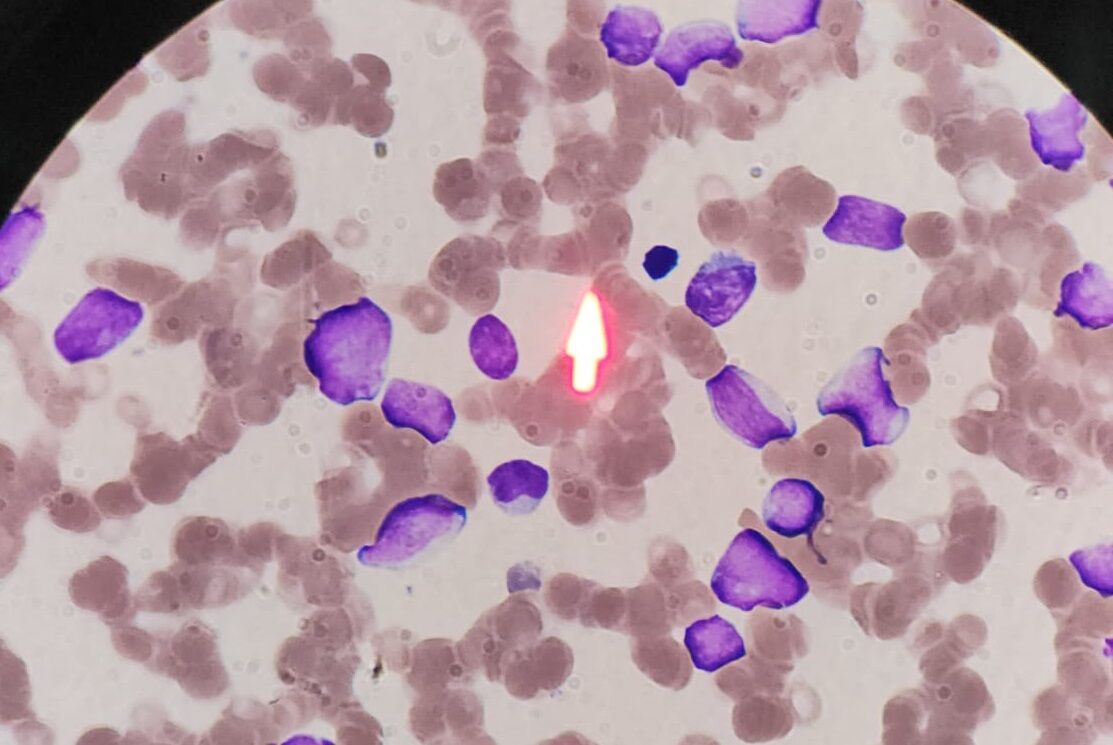
Whatsapp Image 2026 03 06 At 12.51.50 (2)

Son yıllarda hızla gelişen hematoloji tedavilerini yakından takip eden Açar, uyguladığı güncel tedavi yöntemleri ve hastalarıyla kurduğu güçlü iletişim sayesinde bölge halkının güvenini kazanan hekimler arasında gösteriliyor.
2014 yılında İstanbul Üniversitesi Cerrahpaşa Tıp Fakültesi’nden mezun olan Dr. Açar, İç Hastalıkları uzmanlık eğitimini 2019 yılında Gaziantep Üniversitesi Tıp Fakültesi İç Hastalıkları Anabilim Dalı’nda tamamladı. Ardından Çukurova Üniversitesi Tıp Fakültesi Hematoloji Bilim Dalı’nda aldığı yan dal eğitimiyle 2023 yılında hematoloji uzmanı oldu.
Aynı yıl Devlet Hizmeti Yükümlülüğü (DHY) kapsamında Osmaniye Devlet Hastanesi’ne atanan Dr. Açar, burada kısa sürede birçok başarılı tanı ve tedaviye imza atarak dikkat çekti. 2024 yılında Doçentlik unvanını alan Açar, daha sonra Gaziantep Şehir Hastanesi Hematoloji Kliniği’nde görev alarak Gaziantep ve çevre illerden gelen hastalara hizmet vermeye başladı.
Hematoloji; iyi huylu ve kötü huylu kan hastalıklarının tanı, tedavi ve takibiyle ilgilenen kritik bir tıp dalıdır. Bu kapsamda lösemiler (AML, ALL, KML, KLL), lenfomalar (Hodgkin ve Non-Hodgkin lenfoma), Multiple Myelom, Miyelodisplastik Sendrom, kronik miyeloproliferatif hastalıklar, hemoglobinopatiler, anemiler, hemofili ve trombofili gibi birçok hastalığın tanı ve tedavisi bu branşın sorumluluğundadır. Kemik iliği nakli gibi ileri tedavi yöntemleri de hematoloji alanının önemli uygulamaları arasında yer almaktadır.
Gaziantep Şehir Hastanesi’nde görev yapan Doç. Dr. İbrahim Halil Açar, özellikle son yıllarda gelişen hedefe yönelik tedaviler, immünoterapiler ve kişiselleştirilmiş tedavi yaklaşımlarını hastalarının tedavi süreçlerine entegre eden hekimler arasında bulunuyor.
Göreve başladığı günden bu yana yalnızca bir yıl içinde 10 binden fazla hasta ileri tetkik ve tedavi amacıyla Dr. Açar’a başvurdu. Yapılan tanı ve uygulanan modern tedaviler sayesinde birçok hastada yüz güldürücü sonuçlar elde edildiği belirtiliyor.

Hastalar tarafından merhametli yaklaşımı, bilimsel gelişmeleri yakından takip eden hekimliği ve yüksek hasta memnuniyeti ile tanınan Doç. Dr. Açar, tedavi sürecinde hastalarıyla kurduğu güven ilişkisi sayesinde bölgenin öne çıkan hematoloji uzmanlarından biri olarak gösteriliyor.
Uzmanlar ise kan hastalıklarında erken tanı ve düzenli takibin hayat kurtarıcı olduğunu vurgularken, Gaziantep Şehir Hastanesi Hematoloji Kliniği’nin bölge için giderek daha önemli bir referans merkezi haline geldiğine dikkat çekiyor.



















